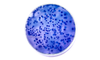
Akkermansia : Bienfaits, Propriétés et Conseils d'utilisation

Le rôle clé du microbiote dans le métabolisme, la satiété et l’énergie
Le microbiote intestinal est l’ensemble des micro-organismes vivant dans notre intestin. Il agit comme un chef d’orchestre invisible de notre santé métabolique, influençant :
- la gestion de l’énergie issue de l’alimentation,
- la satiété et les envies alimentaires,
- la barrière intestinale et l’inflammation de bas grade,
- la sensibilité à l’insuline.
Des déséquilibres du microbiote sont associés à une moins bonne régulation du poids, à des fringales plus fréquentes et à une énergie fluctuante, même chez des personnes qui font attention à leur alimentation et à leur activité physique.
The Role of Probiotics in Modulating Gut Microbiota and Metabolic Health for Weight Management: A Mini Review - Qutaibah Oudat et al. Acta Microbiol. Hell. 2025.
Pourquoi Akkermansia Complexe est une formule experte
Akkermansia Complexe combine plusieurs ingrédients soigneusement choisis pour agir de façon complémentaire sur le microbiote, la digestion, la gestion de l’énergie et la satiété — en s’appuyant sur les dernières données scientifiques.
Akkermansia muciniphila MucT™ – une bactérie clé du microbiote
Cette bactérie est naturellement présente dans l’intestin et a été mise en avant par la recherche pour son rôle dans l’équilibre métabolique et l’intégrité de la barrière intestinale.
Akkermansia muciniphila: biology, microbial ecology, host interactions and therapeutic potential. Athanasia Ioannou et al. Nature Reviews Microbiology. 2025.
Des études montrent que des niveaux plus élevés d’Akkermansia sont associés à une meilleure santé métabolique et à une régulation plus favorable du métabolisme du glucose et de l’énergie.
Akkermansia muciniphila: A key player in gut microbiota-based disease modulation. Nida Shaheen et al. Microbiological Research December 2025.
Une étude récente publiée dans Nature Medicine (2026) confirme l’intérêt scientifique porté à Akkermansia muciniphila dans la gestion du poids et l’équilibre métabolique après un régime.
Après une supplémentation quotidienne en Akkermansia muciniphila MucT™ pasteurisée :
- Reprise de poids limitée dans le groupe Akkermansia : +1,2 kg vs +3,2 kg placebo
- Perte de poids globale plus importante : −3,1 kg supplémentaires vs placebo
- Meilleure réponse métabolique chez les sujets les plus riches en Akkermansia
- Soutient des paramètres cardiométaboliques
Ces résultats viennent renforcer les données scientifiques sur le rôle d’Akkermensia muciniphila dans la régulation du métabolisme du glucose, de l’énergie et du maintien du poids.
Mount, S., Canfora, E.E., Jocken, J.W. et al. Pasteurized Akkermansia muciniphila MucT for weight loss maintenance in people with overweight and obesity: a controlled randomized trial. Nature Medicine (2026)
Nos solutions fonctionnelles accompagnent le bien-être et ne remplacent pas le conseil médical.
Akkermansia Complexe utilise une forme pasteurisée et hautement stable de cette souche brevetée, ce qui permet d’obtenir des résultats réplicables tout en garantissant une sécurité optimale.
De nombreuses recherches scientifiques ont été menées sur Akkermansia, mais à ce jour, la législation européenne n'a pas encore approuvé officiellement ses bienfaits pour la santé. Toutes les études à son sujet sont consultables sur PubMed.
Focus ingrédient — Akkermansia muciniphila MucT™ (forme pasteurisée, “postbiotique”)
La souche MucT™ (ATCC BAA-835) est la souche de référence utilisée dans de très nombreuses publications scientifiques (>300).
Pourquoi une forme pasteurisée ?
Contrairement à un probiotique “vivant”, Akkermansia Complexe utilise une forme pasteurisée, plus stable et plus standardisée. Cette approche s’appuie sur des travaux montrant que l’activité d’Akkermansia peut être conservée (et, dans certains modèles, renforcée) après pasteurisation, car une partie des effets est liée à des composants de surface.
Mode d’action
Akkermansia agit au niveau de l’écosystème intestinal, avec plusieurs leviers complémentaires :
- Soutien de la barrière intestinale : une barrière intestinale plus robuste aide à mieux contrôler le passage de certains composés bactériens dans le sang.
- Rôle clé d’une protéine : Amuc_1100 : les recherches ont identifié une protéine de membrane externe appelée Amuc_1100, décrite comme thermostable (donc compatible avec la pasteurisation) et capable d’interagir avec des voies impliquées dans l’intégrité de la muqueuse et divers axes de signalisation (notamment métaboliques).
Dit autrement : même “inactivée”, Akkermansia peut garder une activité grâce à des composants fonctionnels — c’est l’idée des postbiotiques.
- Autour de l’inflammation et du terrain métabolique : quand l’intestin est fragilisé, cela peut contribuer à une inflammation souvent associée à un métabolisme moins fluide. Les travaux mécanistiques autour d’Akkermansia et d’Amuc_1100 s’inscrivent précisément dans cette logique de soutient à la barrière intestinale.
Akkermansia a évaluée chez l’Homme en étude de très hauts niveaux (randomisée, double aveugle, placebo) chez des personnes avec un terrain métabolique défavorable et les résultats ont été concluants.
Uniquement la souche MucT™ est évaluée au niveau européen (EFSA) et autorisée dans l’UE, ce qui encadre strictement la qualité et la sécurité de l’ingrédient.
Supplementation with Akkermansia muciniphila in overweight and obese human volunteers: a proof-of-concept exploratory study. Clara Depommier et al. Wageningen university research - Nature Medicine 2019
Akkermansia muciniphila: biology, microbial ecology, host interactions and therapeutic potential. Athanasia Ioannou et al. Nature Reviews Microbiology 2025
Akkermansia muciniphila: A key player in gut microbiota-based disease modulation. Nida Shaheen Microbiological research 2025.
Lactobacillus gasseri – confort digestif et gestion abdominale
Le Lactobacillus gasseri a été étudiées chez l’humain et associé à des effets bénéfiques sur le bon fonctionnement de la muqueuse intestinale mais aussi de la graisse abdominale, du tour de taille et du poids corporel par rapport à un placebo dans des essais cliniques.
Effect of Lactobacillus gasseri SBT2055 in fermented milk on abdominal adiposity in adults in a randomised controlled trial. Yukio Kadooka et al. Cambridge University Press 2013.
De nombreuses recherches scientifiques ont été menées sur le L. gasseri, mais à ce jour, la législation européenne n'a pas encore approuvé officiellement ses bienfaits pour la santé. Toutes les études à son sujet sont consultables sur PubMed.
Ce probiotique contribue à renforcer l’équilibre global du microbiote et complète l’action d’Akkermansia sur l’énergie et la gestion du poids.
Bifidobacterium lactis – soutien du confort et de l’équilibre intestinal
Les bifidobactéries sont des membres essentiels du microbiote sain. B. lactis aide à soutenir la régularité digestive et un environnement intestinal confortable, conditions préalables à un métabolisme fluide et efficace.
Chrome et Vitamine B1 – soutien métabolique global
Le chrome est reconnu pour contribuer au métabolisme normal des macronutriments et à la glycémie normale (appuyé par des avis scientifiques réglementaires).
La vitamine B1 contribue à un métabolisme énergétique normal.
Leur présence dans la formule aide à ancrer les effets microbiotiques dans un contexte métabolique global, pour une meilleure utilisation de l’énergie par l’organisme.
Comment cette formule agit ensemble
- Agit sur le microbiote en favorisant une population bactérienne bien équilibrée.
- Soutient l’intégrité intestinale et la communication métabolique (barrière, hormones de satiété).
- Soutient la gestion de l’énergie et du stockage grâce à une synergie de souches, micronutriments et co-facteurs.
- Contribue à un confort digestif durable, base d’un métabolisme plus efficace.
Akkermansia Complexe s’appuie à la fois sur :
- une approche microbiotique moderne,
- des souches documentées scientifiquement,
- des ingrédients complémentaires cohérents avec des fonctions métaboliques connues.
C’est une formule complète et experte – une innovation de dernière génération pensée pour accompagner naturellement votre métabolisme, votre énergie, votre satiété et votre confort digestif.
Elle ne remplace pas une alimentation équilibrée ou une activité physique, mais elle agit de l’intérieur pour soutenir durablement votre bien-être métabolique.







 Akkermansia muciniphila Les propriétés d’Akkermansia contribuent à renforcer la barrière intestinale, soutenir l’équilibre du microbiote, la digestion et la santé métabolique.
Akkermansia muciniphila Les propriétés d’Akkermansia contribuent à renforcer la barrière intestinale, soutenir l’équilibre du microbiote, la digestion et la santé métabolique.